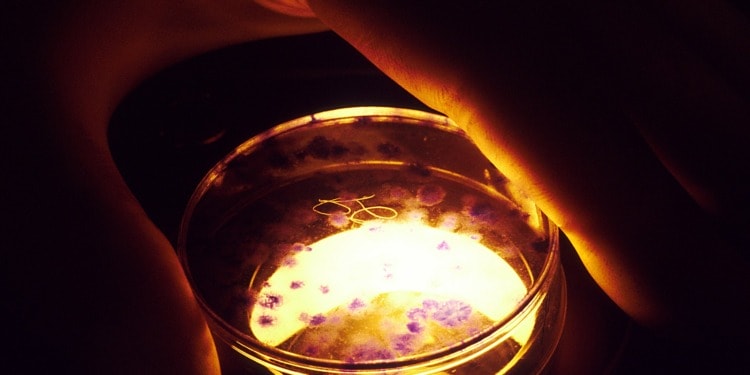
Scientists Create Synthetic Human Embryos

In a groundbreaking scientific advancement that challenges traditional methods of reproduction, scientists have successfully created synthetic human embryos using stem cells.
These synthetic embryos closely resemble the early stages of human development. However, they do not have a beating heart or a brain. Moreover, it contains the type of cells that typically form the placenta, yolk sac and the embryo itself.
The synthetic embryos mimic real human embryos in the early stages of pregnancy. With that, they offer a unique opportunity for researchers to study these often crucial first weeks of pregnancies.
The breakthrough, however, also raises important legal and ethical concerns.
“Human Embryo-like Models”
Professor Magdalena Żernicka-Goetz from the University of Cambridge and the California Institute of Technology presented her team’s work at the International Society for Stem Cell Research’s annual meeting in Boston on Wednesday.
According to Żernicka-Goetz, the synthetic embryos were created entirely from embryonic stem cells. However, the full details of the research are yet to be formally published.
Importantly, the research is said to open the window into the so-called “Black Box” period of embryonic development, namely the time frame after the first two weeks of pregnancies. This is because current laws do not allow scientists to work on human embryos after 14 days of development.
Related Articles: The Importance of Utilizing Stem Cell Research | Dealing with risk – Are we ready to deal with high-impact, complex and uncertain science? | The Future of Bioethics: Organ Transplantation, Genetic Testing, and Euthanasia | What Does It Mean to Be Resilient in STEM?
“I just wish to stress that they are not human embryos,” Zernicka-Goetz said. “They are embryo models, but they are very exciting because they are very looking similar to human embryos and very important path towards discovery of why so many pregnancies fail, as the majority of the pregnancies fail around the time of the development at which we build these embryo-like structures.”
If successful, this discovery could aid in treating genetic disorders and biological miscarriages.
Whether these embryos could survive in a womb or develop into a living creature is unclear. Previous experiments with mice and monkeys had failed to progress further when planted into an animal’s womb.
The Need for Legislation on Synthetic Human Embryos
Undeniably, the discovery raises important legal and ethical questions. As James Briscoe, Associate Research Director at the Francis Crick Institute said:
“Unlike human embryos arising from in vitro fertilisation (IVF), where there is an established legal framework, there are currently no clear regulations governing stem cell-derived models of human embryos. There is an urgent need for regulations to provide a framework for the creation and use of stem cell-derived models of human embryos.”
It remains open to see the limits of this discovery. Scientists agree, however, that transparency and guidelines will be essential to put in place. Some are even said to be creating voluntary guidelines.
Editor’s Note: The opinions expressed here by the authors are their own, not those of Impakter.com — In the Featured Photo: A tissue culture dish mounted under a microscope for viewing by a technician. Featured Photo Credit: Linda Bartlett.